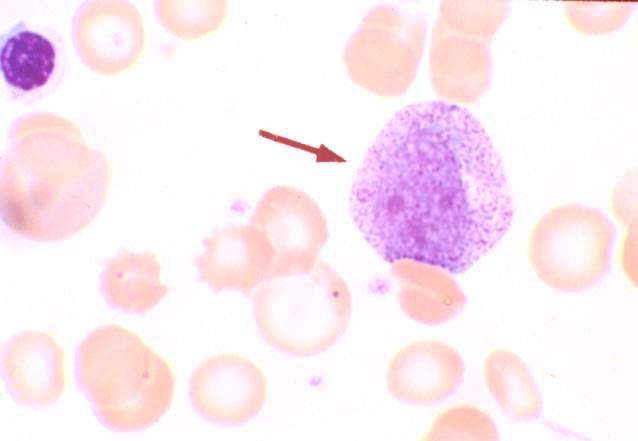
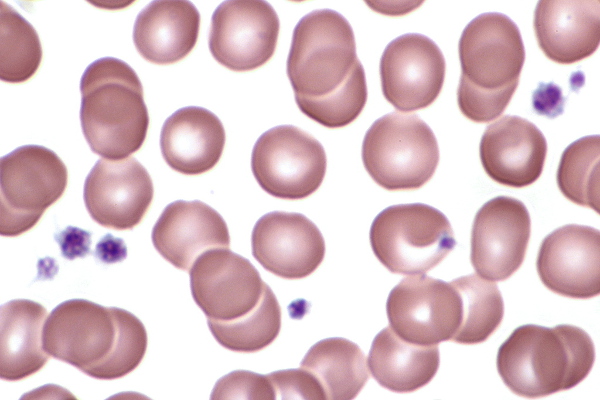

아주르친화성 과립
"오늘의AI위키"의 AI를 통해 더욱 풍부하고 폭넓은 지식 경험을 누리세요.
1. 개요
아줄친화성 과립은 과립구, 림프구, 단핵구, 거핵구 및 혈소판 등 다양한 혈액 세포에서 발견되는 과립을 의미한다. 과립구의 일차 과립(아줄 과립)은 미생물을 죽이는 데 중요한 역할을 하는 미엘로페르옥시다아제, 디펜신, 리소자임 등의 항균 물질을 포함한다. 림프구 중 대과립 림프구는 아줄 과립 내 세포 손상성 물질을 통해 세포성 면역 기능을 수행하며, 림프계 악성 종양에서도 관찰될 수 있다. 단핵구의 아줄친화성 과립은 과립구보다 작게 나타나며, 혈소판은 다수의 아줄 과립을 가지며 혈액 응고 과정에 관여한다.
더 읽어볼만한 페이지
- 염색 (생물학) - H&E 염색
H&E 염색은 헤마톡실린과 에오신을 사용하여 조직의 핵은 파란색 또는 보라색으로, 세포질은 분홍색 또는 붉은색으로 염색하는 조직학적 염색법이다. - 염색 (생물학) - 질-닐슨 염색
질-닐슨 염색은 결핵균 등 항산성 세균 검출을 위해 개발된 염색 방법으로, 석탄산 푹신으로 1차 염색 후 산성 알코올로 탈색하고 대비 염색하여 항산성 세균을 붉은색으로, 비항산성 세균을 다른 색으로 염색한다. - 혈액학 - 색전증
색전증은 혈관을 막는 색전이 혈류를 따라 이동하여 발생하는 질환으로, 혈전, 지방, 종양 등 다양한 원인에 의해 발생하며, 동맥 또는 정맥에서 혈류 차단으로 인한 장기 부전을 유발한다. - 혈액학 - 지혈
지혈은 혈관 수축, 혈소판 마개 형성, 혈액 응고 과정을 통해 출혈을 막는 신체의 고유한 반응이며, 다양한 방법으로 이루어지고 응급 처치에 사용되며, 관련 질환과 약물, 유전적 요인이 지혈에 영향을 미친다.
2. 과립구
과립구는 다형핵 백혈구라고도 하며, 호중구, 호산구, 호염기구를 포함한다. 과립구는 미생물을 죽이거나 조직을 소화하는 성분을 포함하는 과립을 갖는 것이 특징이다.
과립구의 과립에는 아줄 과립(1차 과립)과 Specific granule|특이 과립영어 (2차 과립. 호중구의 경우 3차 과립도 있다)이 있다. 특이 과립은 과립구에서만 볼 수 있으며, 특이 과립의 염색상의 거동에 따라 과립구는 호중구(미세한 적갈색 과립), 호산구(조대한 등적색 과립), 호염기구(조대한 청흑색 과립)의 세 종류로 나뉜다.[8][9]
2. 1. 일차 과립 (아주르 과립)
아주르 과립은 특정 종류의 혈액 세포의 세포질에 존재하는, 로마노프스키 염색(메이-그륀발트-김자 염색, 라이트 염색, 김자 염색 등)의 아주르 염료[4]로 염색되어 자색에서 자적색을 띠는 과립으로, 아주르 친화성 과립이라고 불리기도 한다.[13][9]과립구(다형핵 백혈구)는 호중구, 호산구, 호염기구를 포함하며, 미생물을 죽이거나 조직을 소화하는 성분을 포함하는 과립을 갖는 것이 특징이다. 과립구의 과립에는 아줄 과립(1차 과립)과 Specific granule|특이 과립영어(2차 과립, 호중구는 3차 과립도 존재)이 있다. 특이 과립은 과립구에서만 볼 수 있으며, 염색상의 거동에 따라 호중구(미세한 적갈색 과립), 호산구(조대한 등적색 과립), 호염기구(조대한 청흑색 과립)로 나뉜다.[8][9]

모든 과립구에는 일차 과립이라고 불리는 아줄 과립이 존재한다. 골수아세포 단계에서는 세포질에 과립이 없지만, 전골수구가 되면 먼저 일차 과립(아줄 과립)이 나타난다.[5] 골수구 단계에서는 일차 과립 생성이 멈추고, 해당 백혈구 종류에 특징적인 색으로 염색되는 특이 과립(이차 과립)이 생성되기 시작한다. 골수구는 분열 증식하므로 세포당 일차 과립 수는 감소하며, 염색성도 변화한다.[6] 성숙한 과립구에서는 라이트 염색으로 담청자색으로 염색되지만, 계속해서 아줄 과립이라고 불리는 경우가 있다.[19] 중증 감염증 등에서는 독성 과립이 호중구 세포질에서 관찰될 수 있는데, 이는 어린 아줄 과립으로 생각된다.
일차 과립은 미엘로페르옥시다아제를 포함하므로, 페르옥시다아제 염색으로 특이 과립과 구별할 수 있다.
일차 과립은 다음과 같은 항균 물질을 대량으로 함유하고, 식포와 융합하여 탐식된 미생물을 죽이는 데 중요한 역할을 한다.
- 미엘로페르옥시다아제: 과산화 수소와 염소 이온으로부터 차아염소산 이온을 생성하여 살균 작용을 한다. 호중구 건조 중량의 5% 정도를 차지하며, 고름이 녹색으로 보이는 원인이다.
- 디펜신: 양이온성 단백질로 각종 세균, 진균, 바이러스를 죽이는 작용을 하며, 호중구 단백질의 거의 5% 정도를 차지한다.
- 리소자임: 세균 세포벽의 펩티도글리칸을 분해한다 (리소자임은 특이 과립에도 포함).
- 아주로시딘: 항균·항진균 활성을 갖는다.
일차 과립은 호중구 엘라스타제, 카텝신 G 등의 프로테아제(단백질 분해 효소)도 포함하며, 세포 외로 방출되어 병원체 제거 및 국소 염증 과정 제어에 관여한다.[18][19]
2. 2. 일차 과립 관련 구조물
모든 과립구에는 일차 과립이라고 불리는 아줄 과립이 존재한다.과립구의 골수에서의 분화 과정에서, 골수아세포 단계에서는 세포질에 과립이 없고, 전골수구가 되면 먼저 일차 과립(아줄 과립)이 나타난다.[5] 골수구 단계에서는 일차 과립의 생성이 멈추고, 해당 백혈구 종류에 특징적인 색으로 염색되는 특이 과립(이차 과립)이 생성되기 시작한다.
골수구도 분열 증식하므로, 세포당 일차 과립의 수는 감소해 간다. 또한, 일차 과립의 염색성도 변화해 가고[6], 성숙한 과립구에서는 라이트 염색으로 담청자색으로 염색되게 된다[19] (염색성이 변화해도, 계속해서 아줄 과립이라고 불리는 경우가 있다). 중증 감염증 등으로 독성 과립이 호중구 세포질에서 관찰될 수 있는데, 이는 어린 아줄 과립으로 생각된다.
일차 과립은 미엘로페르옥시다아제를 포함하므로, 페르옥시다아제 염색으로 특이 과립과 구별할 수 있다.
일차 과립은 식포와 융합하여 탐식된 미생물을 죽이는 데 중요한 역할을 하는 각종 항균 물질을 대량으로 함유하고 있다. 예를 들면 다음과 같다.
- 미엘로페르옥시다아제: 과산화 수소와 염소 이온으로부터 차아염소산 이온을 생성하여 살균 작용을 발휘한다. 호중구 건조 중량의 5% 정도를 차지하며, 고름이 녹색으로 보이는 원인이다.
- 디펜신: 양이온성 단백질로 각종 세균, 진균, 바이러스를 죽이는 작용을 하며, 호중구 단백질의 거의 5% 정도를 차지한다.
- 리소자임: 세균 세포벽의 펩티도글리칸을 분해한다 (리소자임은 특이 과립에도 포함되어 있다).
- 아주로시딘: 항균·항진균 활성을 갖는다.
일차 과립은 그 외에도 호중구 엘라스타제, 카텝신 G 등의 프로테아제 (단백질 분해 효소)를 포함하고 있으며, 세포 외로 방출되어 병원체의 제거 및 국소 염증 과정의 제어에 관여한다[18][19]。
독성 과립은 염증 등과 관련하여 호중구의 세포질에서 보이는 아줄친화성 과립으로, 미숙한 상태의 일차 과립으로 여겨진다. 자세한 내용은 독성 과립 문서를 참고하면 된다.
아우에르 소체는 골수계 백혈병 세포(주로 골수아세포와 전골수구)의 세포질에서 볼 수 있는, 아주르 친화성의 바늘 모양에서 막대 모양의 봉입체이며, 일차 과립이 융합된 것으로 생각된다. 자세한 내용은 아우에르 소체 문서를 참고하면 된다.
3. 림프구

말초 혈액 속 림프구의 대부분은 세포질이 빈약하고 세포질 과립도 보이지 않는 소 림프구이다. 그러나 일부 림프구는 크기가 크고 풍부한 세포질에 아주르 과립을 가지는데, 이를 대과립 림프구(LGL)라고 한다.
3. 1. 대과립 림프구 (LGL)
말초 혈액 속 림프구의 대부분은 세포질이 빈약하고 세포질 과립도 보이지 않는 소 림프구이다. 그러나 림프구 중에는 크기가 크고 풍부한 세포질에 아주르 과립을 가진 것이 있으며, 이를 대과립 림프구 (large granular lymphocyte, LGL)라고 부른다.
대과립 림프구는 건강한 사람의 말초 혈액 중 림프구의 10-15% 정도 존재하며 세포성 면역을 담당하는 T 세포형과 NK 세포형이 있다. 대과립 림프구는 자가면역 질환, 거대세포바이러스 등의 바이러스 감염, 조혈모세포 이식, 장기 이식 등에서 증가하는 것 외에, 과립 림프구 증가증/대과립 림프구성 백혈병에서 현저한 증가를 보인다.
대과립 림프구의 아줄 과립에는 퍼포린, 그랜자임 등의 세포 손상성 물질이 포함되어 있으며, 세포성 면역 기능을 발휘하여 종양 세포나 바이러스 감염 세포를 파괴하는 데 중요한 역할을 한다.
3. 2. 림프계 악성 종양
대과립 림프구 백혈병 외에 아주르친화성 과립을 가지는 림프계 악성 종양으로는 NK 세포성 및 T 세포성 악성 림프종이 잘 알려져 있다. B 세포성 악성 종양으로는 종격동 원발 대세포 림프종, 털세포 백혈병, 드물게 소 림프구 림프종/백혈병, MALT 림프종[14], 급성 림프구성 백혈병(ALL)[16], 골수종[17] 등에서도 보고가 있다.4. 단핵구

단구의 세포질 과립에도 과산화효소를 포함하는 것이 있지만, 단구의 과립은 과립구보다 훨씬 작으며, 광학 현미경으로는 미세한 과립에 의해 세포질이 서리 유리처럼 흐릿하게 보이는 것이 보통이다. 그러나 상황에 따라 단구의 핵 주위에 자홍색의 아줄 과립을 확인할 수 있다.[9][19]
5. 거핵구 및 혈소판


혈소판은 옅은 청색 세포질 안에 다수의 미세한 아줄 과립을 가지고 있다. 아줄 과립은 혈소판 중심부에 모이는 경우가 많아, 핵이 있는 것처럼 보이기도 한다.[4][13][9]
전자 현미경으로 관찰하면 혈소판 세포질에는 거핵구에서 생성된 다수의 α과립과 소수의 농염 과립(δ과립)이 있다. α과립에는 β-트롬보글로불린, 혈소판 제4인자, 혈소판 유래 성장 인자, 피브리노겐, 폰 빌레브란트 인자 등이 들어있다. δ과립에는 ADP, ATP, 세로토닌, 칼슘 이온 등 혈소판 방출 반응을 유발하는 물질이 포함되어 있다. 혈소판이 활성화되면 이러한 과립의 내용물이 세포 밖으로 방출된다.[10]
거핵구 및 혈소판의 아줄 과립은 대부분 α과립으로 생각된다. α과립의 선천적 결손인 α과립 이상증(회색 혈소판 증후군)에서는 혈소판 세포질에서 과립을 확인할 수 없어, 혈소판이 회청색으로 보인다.[11]
참조
[1]
웹사이트
Phagocytes-Neutrophils
http://www.dent.ucla[...]
[2]
서적
Wintrobe's clinical hematology
https://books.google[...]
Lippincott Williams & Wilkins
2008-12-01
[3]
서적
Exotic Animal Medicine for the Veterinary Technician
Wiley-Blackwell
2010-05-04
[4]
문서
아즈ール色素は、[[メチレンブルー]]の酸化で生成する、アズールA、アズールB、アズールCなどの、青から青紫色の色素である。[[塩基性]]色素であり、水溶液中では陽性に荷電して、陰性に荷電している[[核酸]]などの[[酸性]]物質と結合する。
[5]
문서
[[急性前骨髄球性白血病]]でよくみられる[[アウエル小体]]は、アズール顆粒に由来すると考えられている。
[6]
문서
一次顆粒の染色性が変化する理由は、酸性の粘液物質が増加して顆粒内の塩基性の蛋白と結合するためと考えられている。
[7]
문서
'[http://www.intercyto.com/lecture/manual/fluid_manual.pdf 細胞診標本作成マニュアル「体腔液」. 細胞検査士会ホームページ ]'
http://www.intercyto[...]
[8]
문서
カンゴルー用語辞典 「顆粒球」
https://www.kango-ro[...]
[9]
서적
臨床検査法提要
金原出版株式会社
[10]
학술지
活性化血小板に由来する生理活性物質:臨床への展望
https://doi.org/10.2[...]
2008
[11]
문서
小児慢性特定疾病情報センター 診断の手引き 34血小板放出機構異常症
https://www.shouman.[...]
2022-11-21
[12]
학술지
T-cell and natural killer-cell large granular lymphocyte leukemia neoplasias
https://doi.org/10.3[...]
Taylor & Francis
[13]
문서
顆粒リンパ球. 押味和夫. 特定非営利活動法人 Asia Lymphoma Network <アジア リンフォーマ ネットワーク>
https://asia-lym-net[...]
2022-11-22
[14]
학술지
Azur顆粒を認めた胃MALTリンパ腫の1例
https://doi.org/10.5[...]
[15]
학술지
Large Granular Lymphocyte Expansion in Myeloid Diseases and Bone Marrow Failure Syndromes: Whoever Seeks Finds
https://doi.org/10.3[...]
Frontiers Media SA
[16]
학술지
Azurophilic granular blasts are not always part of myeloid lineage: an atypical case of BCP acute lymphoblastic leukemia
https://doi.org/10.1[...]
[17]
학술지
Azurophilic granules in myeloma cells
https://doi.org/10.1[...]
[18]
학술지
Roles of neutrophil granule proteins in orchestrating inflammation and immunity
https://doi.org/10.1[...]
[19]
서적
Wintrobe's clinical hematology
https://books.google[...]
Lippincott Williams & Wilkins
[20]
웹인용
Phagocytes-Neutrophils
http://www.dent.ucla[...]
[21]
서적
Wintrobe's clinical hematology
https://books.google[...]
2010-11-10
[22]
서적
Exotic Animal Medicine for the Veterinary Technician
https://archive.org/[...]
본 사이트는 AI가 위키백과와 뉴스 기사,정부 간행물,학술 논문등을 바탕으로 정보를 가공하여 제공하는 백과사전형 서비스입니다.
모든 문서는 AI에 의해 자동 생성되며, CC BY-SA 4.0 라이선스에 따라 이용할 수 있습니다.
하지만, 위키백과나 뉴스 기사 자체에 오류, 부정확한 정보, 또는 가짜 뉴스가 포함될 수 있으며, AI는 이러한 내용을 완벽하게 걸러내지 못할 수 있습니다.
따라서 제공되는 정보에 일부 오류나 편향이 있을 수 있으므로, 중요한 정보는 반드시 다른 출처를 통해 교차 검증하시기 바랍니다.
문의하기 : help@durumis.com